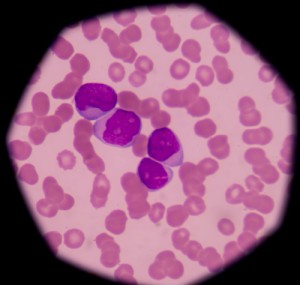

sicuramente non è di origine umana”, e ancora è da comprendere che origine abbia, se sia virale o batterica. Questa la scoperta frutto della collaborazione pluriennale fra i ricercatori dell’Università di Milano guidati dal genetista Alessandro Beghini e gli ematologi dell’Ospedale di Niguarda diretti da Roberto Cairoli, pubblicata su Scientific Reports. La scoperta apre sicuramente nuove possibilità di cura per una malattia che in Italia si stima colpisca oltre 2.000 persone.
Lo studio
I ricercatori non parlano di ‘origine infettiva’ perché “non è prefigurabile – precisano – una trasmissione della leucemia da persona a persona. Resta da capire come una sequenza di DNA alieno, non umano, possa essere entrata in una cellula umana”. Il lavoro è stato completamente autofinanziato e ha ricevuto il sostegno delle Associazioni di Volontariato (Associazione Malattie del Sangue-Milano, Como Hematology and Oncology, Como) senza finanziamenti dalle case farmaceutiche.
Già in uno studio di 4 anni fa delle due equipe milanesi, si era visto che la proliferazione cellulare incontrollata, tipica dei meccanismi tumorali, presentava nelle cellule leucemiche un’iper-espressione della proteina WNT10B. “Siamo andati a ritroso – spiega Cairoli – e ci siamo chiesti chi impartisse questo ordine in grado di attivare una proliferazione cellulare senza interruzione”.
“Inoltre – aggiunge Beghini – grazie a una serie di tecniche di biologia molecolare molto avanzate partendo dalla proteina sovraespressa siamo riusciti, a identificare una variante dell’oncogene WNT10B, e lo abbiamo studiato”. E’ come se i ricercatori avessero ‘zoomato’ sulla sequenza individuata per delinearne le caratteristiche. E nell’area interruttore, che regola l’espressione o lo spegnimento del gene, ecco la scoperta: si sono trovati di fronte a una sequenza di nucleotidi (i mattoni che costituiscono il DNA) “che sicuramente non è di origine umana”.
E il sospetto è andato subito a potenziali virus o batteri coinvolti nella malattia. Singolare che a fare la differenza sia stato l’utilizzo di sequenziatori automatici non modernissimi: una vera fortuna per Beghini e Cairoli “perché i macchinari di ultima generazione avrebbero scartato le sequenze non umane in automatico senza analizzarle”. L’anomalia ‘con l’intruso’ è stata riscontrata nel 56% delle leucemie mieloidi acute e il materiale genetico analizzato è stato estratto da una casistica di 125 pazienti trattati per questo tumore presso l’Ematologia di Niguarda nel corso degli ultimi 5 anni.
La scoperta apre la strada a una ‘pista microbiologica’ con virus e batteri coinvolti nel meccanismo patologico di questa leucemia anche se è presto per prefigurare uno scenario preciso. Anzi, sarà necessaria una serie di approfondimenti per risalire alla specie a cui il DNA appartiene e per chiarire i meccanismi della sua all’incorporazione nelle cellule umane. Ma gli studiosi hanno trovato un’altra correlazione che difficilmente potrà passare inosservata: hanno scoperto la stessa alterazione genetica anche in alcune cellule di tumore della mammella.
Le evidenze al momento sono meno approfondite ma è un input di ricerca che potrebbe delineare novità importanti. Nel frattempo le ricadute sul trattamento della leucemia mieloide acuta sono promettenti. Con questa scoperta, infatti, si e’ identificato un nuovo target per le terapie a bersaglio molecolare. I prossimi passi della ricerca si concentreranno sullo sviluppo di nuovi farmaci che vadano a stoppare in modo mirato i meccanismi proliferativi mediati da WNT10B.






Scoperta molto incoraggiante. queste sequenze di DNA anomale non potrebbero essere l’ effetto di mutazioni?
Primi risultati molto promettenti.